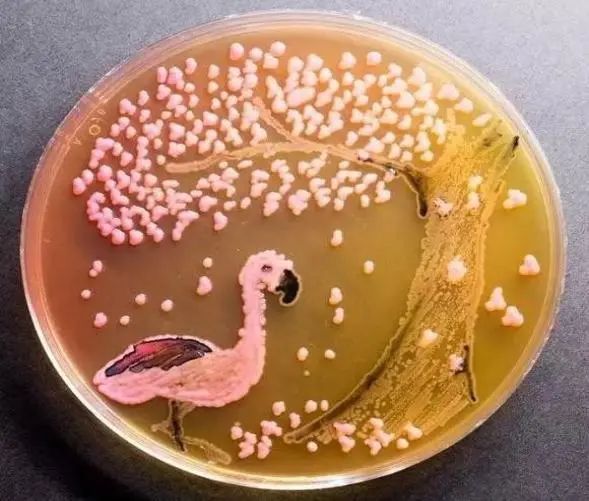

欢迎访问成都市龙泉驿区妇幼保健院 | 三级甲等妇幼保健院
宝宝拉肚子啦,怎么办
莫慌!!!
先来扯cheng头,啥子是腹泻?
腹泻,就是我们川军口中的拉肚子。
腹泻,是指每天大便次数增加,或大便的性质、形状改变,以及粪便变稀薄或含有的黏液、脓血等物质,还可能含有不消化的食物及其他病理性的内容物。有时每天排便可达十几次以上,拉的是昏天黑地的啊。


接下来,切入正题,腹泻患儿日常饮食应该吃啥?
1、腹泻脱水患儿,除严重呕吐者暂禁食4~6小时(不禁水)外,均应继续进食。母乳喂养者继续哺乳,暂停辅食;人工喂养者,可喂以等量米汤、稀释的牛奶或其他代乳品,腹泻次数减少后,给予半流质的粥、面条,少量多餐,也可以吃蒸熟的苹果,有止泻的作用。
2、尽量坚持母乳喂养,如人工喂养应逐步添加辅食,但要切忌几种辅食同时添加。婴儿避免夏季断奶。

除了饮食之外,顺便让大家Get一下另一个要命的点:饮食卫生。
食物对了,但是卫生没到位,相当于竹篮打水一场空,还有可能越整越凶。
第一步:洗好手,饭前便后不能少。
第二步:奶瓶餐具洗干净,做好消毒。
奶瓶消毒:不同材质的奶瓶有不同的消毒说明和要求,请按说明规范操作
奶粉是细菌的天然培养皿,不要让孩子的奶瓶成为了细菌的快乐天地。

不洗干净不消毒
奶瓶里就会出现你看到的这个
“树与白鹤”状的细菌菌落
连奶瓶自己都有再泡一泡的冲动,你还有理由懒惰吗?

总的来说:掌握原则,选对食物,做好卫生,便能撑起孩子恢复健康的长廊。